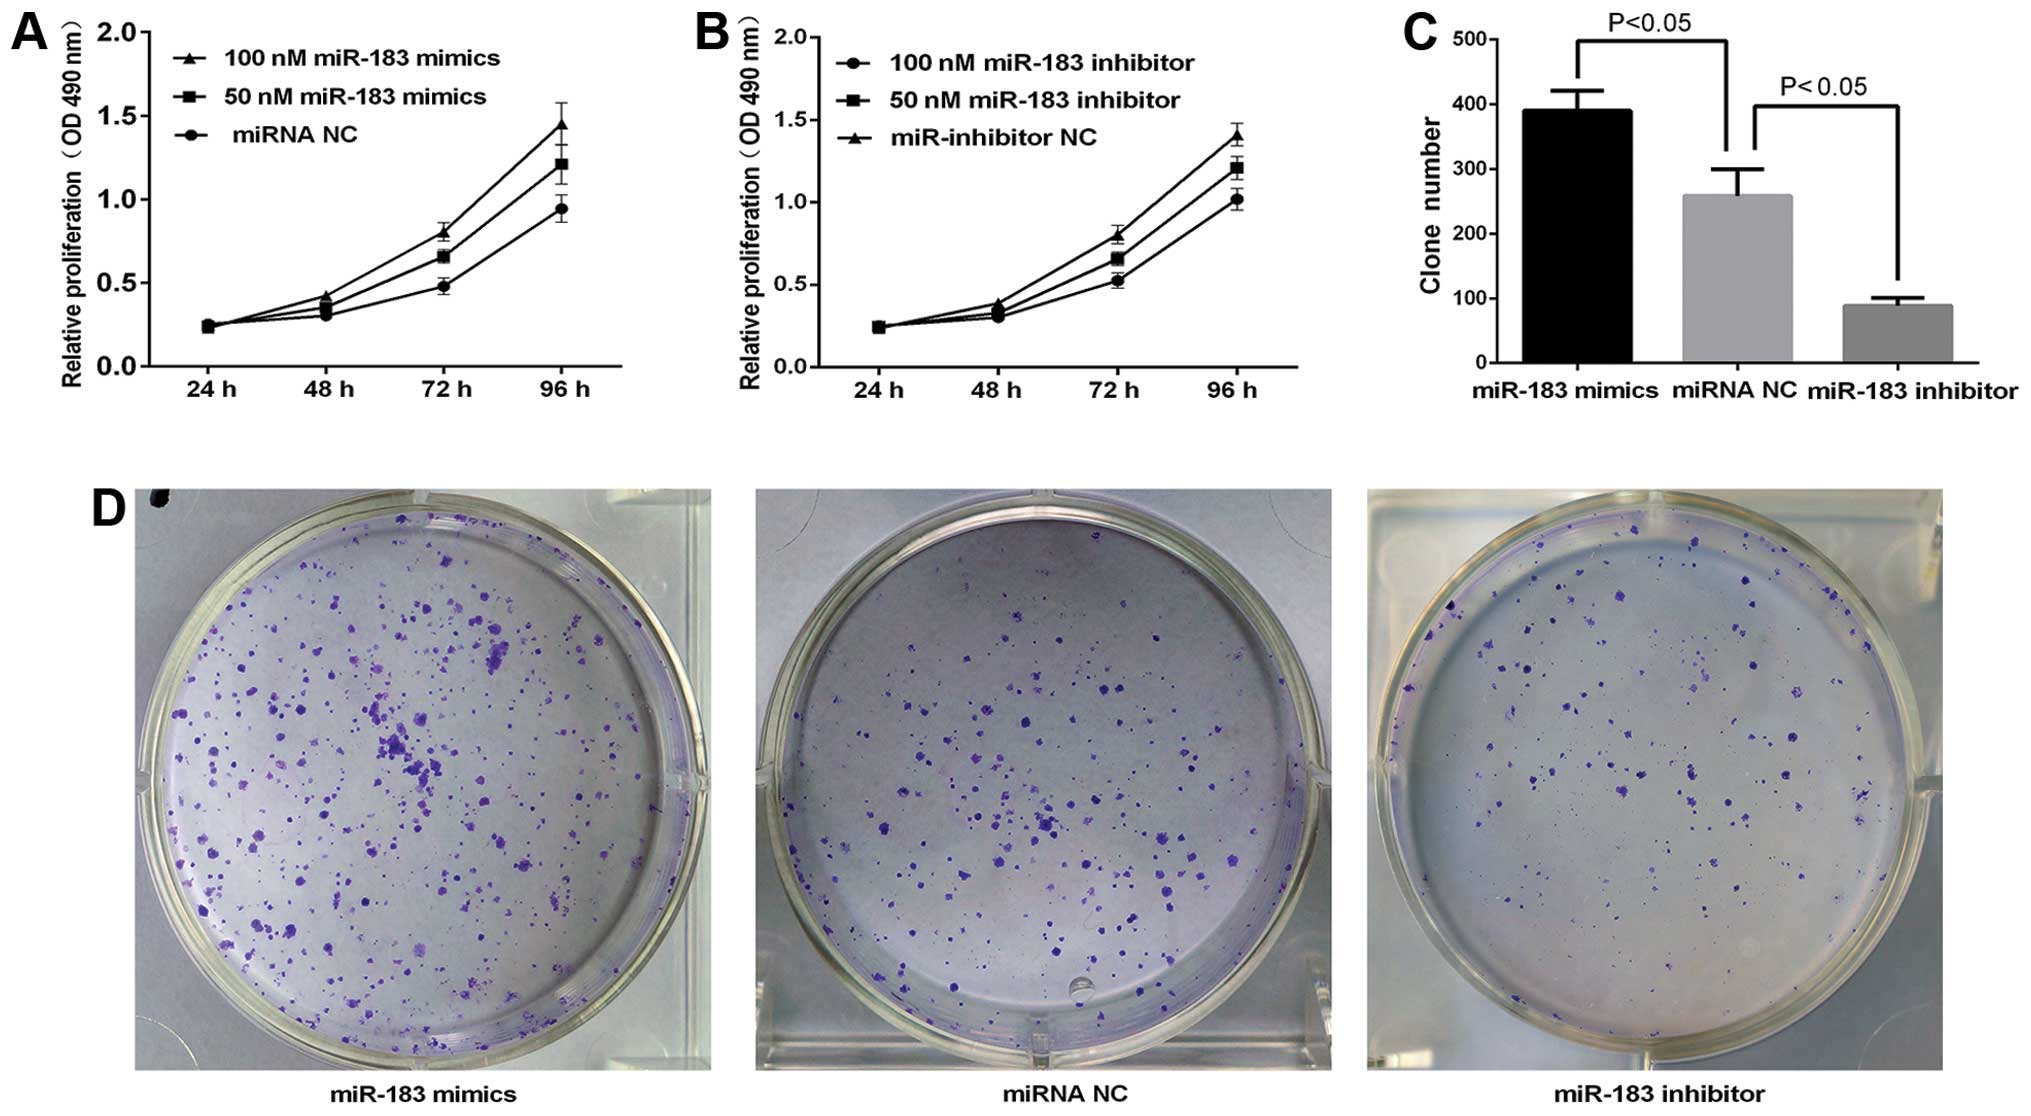

Introduction
Thyroid cancer is the most common endocrine
malignancy and its incidence is on the increase (1,2). Four
main types of thyroid cancer have been identified: papillary,
follicular, medullary and anaplastic thyroid cancer. Papillary
thyroid carcinoma (PTC) is the most frequently occurring type of
thyroid malignancy accounting for ~80–90% of cases (3). This cancer type is the most rapidly
increasing cancer among women and the second most among men
(4), and poses a serious threat to
human health and life.
Although most PTC can be managed successfully with a
combination of radioiodine and levothyroxine treatment after
complete thyroidectomy, tumors with more aggressive phenotype are
associated with morbidity and mortality (5). Thus, understanding the molecular
mechanism of PTC is important for the development of more effective
therapeutic strategies.
MicroRNAs (miRNAs) are a class of small non-coding
RNAs with an approximate length of 21–23 nt, which are highly
conserved. miRNAs regulate the expression of various genes at the
post-transcriptional level by binding to the 3′-untranslated region
(3′-UTR) of their target mRNAs (6–8). When
the miRNA is perfectly complementary to its target, it can
specifically cleave the target mRNA. However, when partially
complementary to its target, the miRNA only represses mRNA
translation (9,10). Although miRNAs constitute only 3% of
the human genome, it is reported that ~90% of genes serve as miRNA
targets. miRNAs are involved in biological processes such as cell
proliferation and differentiation, metabolism, invasion, metastasis
and apoptosis, all of which are associated with tumorigenesis
(11–14). Previous findings showed that >50%
of annotated human miRNAs are located in the fragile sites of the
genome connected with cancer (15).
It has been widely shown that miRNAs are significantly
differentiated between tumor and normal tissues, including thyroid
cancer (16–18), and may act as oncogenes or tumor
suppressor genes (19,20). miR-221, miR-222 and miR-181b have
been found to be upregulated in PTC compared with normal thyroid
tissue (21–23). Using miRNA microarray chip, it was
found that miR-183 was overexpressed in PTC compared with normal
thyroid tissues. However, the roles of miR-183 in PTC and the
mechanism of gene regulation remain to be determined.
Programmed cell death 4 (PDCD4), a
tumor-suppressor gene, has been reported to be involved in tumor
progression, apoptotic machinery, cell transformation and invasion.
PDCD4 protein is downregulated or lost in many human types of
cancer and cancer cell lines (24–31),
including PTC (32,33). Using programs available online, we
determined that miR-183 potentially regulates the PDCD4
gene. Previous results indicated that miR-183 inhibited the
apoptosis of TGF-β1-induce d human hepatocellular carcinoma (HCC)
cells by repressing PDCD4 expression (34). Additionally, miR-183 promotes
proliferation and invasion in oesophageal squamous cell carcinoma
by targeting PDCD4 (35).
Nevertheless, whether miR-183 negatively regulates PDCD4 expression
in papillary thyroid cancer remains to be determined.
In the present study, we investigated whether
miR-183 was upregulated in PTC clinical samples and cell lines. The
ectopic expression of miR-183 induced significant changes of cell
proliferation, migration, invasion and apoptosis by directly
targeting PDCD4. The present study findings identified a novel
strategy for the early diagnosis and treatment of PTC.
Materials and methods
Specimens
In the present study, 38 pairs of papillary thyroid
cancer and adjacent normal thyroid specimens were obtained from the
Department of Breast and Thyroid Surgery of the Shanghai Tenth
People’s Hospital and approved by the Institutional Ethics
Committee of the Shanghai Tenth People’s Hospital (no.
SHSy-ieC-pap-15-1). Each patient provided written informed consent.
The samples were immediately snap-frozen in liquid nitrogen. The
specimens were pathologically confirmed as papillary thyroid
carcinoma. No patients had received any chemotherapy or
radiotherapy prior to surgery.
Cell lines and transfection
The human TPC-1, BCPAP, K1 and NPA PTC cell lines,
human normal thyroid cell line (Nthy-ori 3-1) and HeK293T cells
were purchased from the Chinese Academy of Sciences (Shanghai,
China). TPC-1, K1, NPA and Nthy-ori 3-1 cells were cultured in
RPMI-1640 supplemented with 10% fetal bovine serum (FBS) (both from
Gibco, Carlsbad, CA, USA), penicillin (100 U/ml) and streptomycin
(100 µg/ml) (Enpromise, China). BCPAP and HEK293T cells were
cultured in Dulbecco’s modified Eagle’s medium (DMEM) (Gibco)
supplemented with 10% FBS, 1% penicillin and 1% streptomycin. The
cells were incubated at 37°C with 5% CO2 in saturated
humidity.
miR-183 mimics, inhibitors, PDCD4 siRNA or their
negative control (NC) were purchased from GenePharma (Shanghai,
China). The TPC-1 cells were cultured to 30–40% confluence in
6-well plates (BD Biosciences, Franklin Lakes, NJ, USA) and were
transfected with miR-183 mimics, miR-183 inhibitors, PDCD4 siRNA or
their NC at working concentrations using Lipofectamine 2000
(Invitrogen, Carlsbad, CA, USA), according to the manufacturer’s
instructions. miRNA NC and siRNA NC were used as NCs.
miRNA isolation and
reverse-transcription-quantitative polymerase chain reaction
(RT-qPCR)
miRNAs were harvested from tissues and cells using a
miRcute miRNA Isolation kit (Tiangen, Beijing, China), according to
the manufacturer’s instructions. miR-183 expression levels were
detected using one-step RT-qPCR (EzOmics SYBR qPCR kit). The
miR-183 and U6 primer, and EzOmics SYBR qPCR kit were purchased
from Biomics Biotechnologies Inc. (Jiangsu, China). U6 was used as
an internal control. The miR-183 stem-loop RT primer used was:
5′-GCGAGCACAGAATTAATACGACTCACTATA GGT-3′; miR-183
5′-TATGGCACTGGTAGAATTCACT-3′ (sense), and
5′-GCGAGCACAGAATTAATACGAC-3′ (antisense); while that of U6
stem-loop RT primer was: 5′-GTC
GTATCCAGTGCAGGGTCCGAGGTGCACTGGATACGA CAAAATATGG-3′; U6
5′-TGCGGGTGCTCGCTTCGGC AGC-3′ (sense), and U6
5′-CCAGTGCAGGGTCCGAGGT-3′ (antisense). Briefly, 100 ng RNAs were
added to a 25 µl reaction system containing 12.5 µl
2X master mix, 0.5 µl 50X SYBR-Green, 0.5 µl reverse
transcription primer (10 µM), 0.5 µl sense and
miR-183 primer (10 µM). RT-qPCR was performed on a 7900HT
fast RT-PCR instrument (Applied Biosystems, Singapore) using
SYBR-Green for fluorophore detection. One-step RT-qPCR parameters
were as follows: 37°C for 60 min, 10 min at 95°C, followed by 40
cycles of 20 sec at 95°C, 30 sec at 62°C and 30 sec at 72°C. Each
sample was tested three times.
For the detection of PDCD4 mRNA expression, total
RNA was isolated from tissues and cells using TRIzol (Invitrogen),
and cDNA was generated by reverse transcription using the
PrimeScript RT-PCR kit (Takara, Japan) according to the
manufacturer’s instructions. The primer (GenePharma) sequences used
were: PDCD4 5′-GTTGGC AGTATCCTTAGCATTGG-3′ (sense), and
5′-TCCACATCA GTTGTGCTCATTAC-3′ (antisense); GAPDH 5′-AAGGTC
GGAGTCAACGGATT-3′ (sense), and 5′-CTGGAAGAT GGTGATGGGATT-3′
(antisense). GAPDH mRNA levels were used for normalization. The
RT-qPCR parameters used were: 2 min at 95°C, and then 40 cycles of
15 sec at 95°C and 30 sec at 60°C. The relative expression was
calculated using the relative quantification equation (RQ) =
2−ΔΔCt (36). Each
sample was tested in triplicate.
Cell proliferation assay (MTT assay)
The transfected cells were seeded in 96-well
(1×103 cells/well) culture plates (BD Biosciences) and
incubated at 37°C in 5% CO2. Cell proliferation was
assessed at 24, 48, 72 and 96 h post-transfection using the MTT
assay kit (Sigma, Santa Clara, CA, USA) according to the
manufacturer’s instructions. Briefly, 20 µl (5 mg/ml) MTT
solution was added to each well. After a 4-h incubation, the medium
was replaced with 150 µl dimethylsulfoxide (DMSO; Sigma).
After 10 min of agitation (100 rpm), the absorbance at 490 nm of
each sample was measured by a microplate spectrophotometer
(Bio-Tek, Winooski, VT, USA). Experiments were performed in
biological triplicate and included six replicates.
Colony formation assay
The transfected cells were seeded in 6-well
(1×103 cells/well) culture plates (BD Biosciences).
Incubation at 37°C with 5% CO2 for 7–10 days until
visible cloning was observed in the dish. Subsequently, the culture
medium was removed and the wells were washed twice with
phosphate-buffered saline (PBS). The colonies were fixed with 95%
ethanol for 10 min, dried and stained with 0.1% crystal violet
solution for 10 min. Each plate was then washed three times with
running water. Cell colonies with >50 cells were counted and
photographed. The experiment was performed three times.
Cell migration and invasion assays
A wound-healing assay was used to evaluate the
migratory ability of the transfected cells. The transfected cells
were seeded in 6-well plates at 30×105 cells/well, and
incubated until the cell monolayer reached 100% confluence. The
bottom of the 6-well plates was scratched with a P200 pipette tip.
Detached cells were washed with PBS and replaced with fresh medium.
The scratch widths were measured at 0 and 48 h using an inverted
microscope (50-fold). The experiment was repeated independently
three times.
Transwell invasion assay performed to
evaluate cell invasive ability
Transwells (Corning, Lowell, MA, USA) with a
Matrigel (2 mg/ml)-coated membrane containing 8-mm diameter pores
were washed with serum-free RPMI-1640. RPMI-1640 supplemented with
10% FBS was added to the lower chamber and the Transwell filter was
placed into 24-well plates. The transfected cells (4×104
cells/Transwell) were plated in the top chamber of in 200 µl
serum-free RPMI-1640 with 0.1% BSA. After 18 h incubation at 37°C
in 5% CO2, the cells remaining on the upper membrane
surface were removed using a cotton swab. The cells that invaded
through the membranes were washed with PBS three times, fixed with
10% formalin and stained with 0.5% crystal violet. Five random
fields for each chamber were photographed. To quantify the number
of cells that had invaded, the cells were dissolved in 300
µl 33% glacial acetic acid and the absorbance at 573 nm was
measured using a microplate spectrophotometer.
Apoptosis assay
An apoptosis assay was used to evaluate cell
apoptosis using the Annexin V-FITC/PI apoptosis detection kit
(Beyotime, Jiangsu, China). After 48 h transfection, the cells were
washed three times with ice-cold PBS, trypsinized and centrifuged.
Then, 2.5 µl Annexin V-FITC reagent and 50 µl 1X
binding buffer were added to the cell groups. The cells were then
incubated in the dark for 15 min at room temperature. Subsequently,
5 µl propidium iodide (PI) and 250 µl 1X binding
buffer were added and the cells were incubated in the dark for 5
min at room temperature. The cells were gently resuspended in the
Annexin V incubation reagent at a concentration of
105–106 cells/100 µl. The samples were
then processed by flow cytometry (FACSCanto™ II; BD
Biosciences).
Vector construction and dual-luciferase
reporter assay
The wildtype 3′-UTR of PDCD4 including predicted
miR-183 targeting sites was amplified using PCR amplification using
the Primer Star kit (Takara) according to the manufacturer’s
instructions. The primers used were: sense,
5′-TAATAAGCTACCTTTTGTAAG GCCATGTTTATTATCTAATCATTCCA-3′ and
antisense, 5′-TTGGAATGATTAGATAATAAACATGGCACTTACAA AAGGTAGCTTATT-3′.
The mutant constructs were generated by mutation. The mutant and
wild-type 3′-UTR fragments were subcloned into the XhoI site
in the 3′-UTR of Renilla luciferase of the psiCHeCK-2
reporter vector. The constructed vectors were designated as
PDCD4-wt-vector and PDCD4-mut-vector. For the dual-luciferase
reporter assays, 293T cells were seeded in 12-well plates (BD
Biosciences) and cultured until the cells reached 80–90%
confluence. The PDCD4-wt-vector or PDCD4-mut-vector (0.2 µg)
were co-transfected with 100 nmol/l miR-183 or miRNA NC using
Lipofectamine™ 2000. After 36 h transfection, firefly and
Renilla luciferase activities were measured using
Dual-Luciferase reporter assay kit (Promega, Madison, WI, USA)
according to the manufacturer’s instructions. The firefly
luciferase (FL) activity of each sample was normalized to the
Renilla luciferase (RL) activity. All the experiments were
performed three times.
Western blotting
The protein expression levels were analyzed by
western blot analysis. Forty-eight hours post-transfection, the
cells were washed twice with ice-cold PBS, RIPA lysis buffer
(Beyotime) was added, and the cells were lysed on ice for 30 min,
wiped off, transferred to an EP tube and centrifuged at 12,000 rpm
for 30 min at 4°C. The supernatants were collected and protein
concentrations were quantified using a BCA protein assay kit
(Beyotime). Each sample with 40 µg protein was denatured
with 5X sodium dodecyl sulfate (SDS) loading buffer (Beyotime) at
95°C for 5 min. Subsequently, the protein samples were separated by
10% SDS-polyacrylamide gel and transferred onto PVDF membranes
(both from Beyotime). The membranes were blocked with 5% fat-free
milk for 1 h, and incubated with primary antibodies PDCD4 (1:1,000
dilution; Cell Signaling Technology, Beverly, MA, USA) and β-actin
(1:1,000 dilution; sc-1616-R; Santa Cruz Biotechnology, Inc., Santa
Cruz, CA, USA) as a loading control overnight at 4°C. The membranes
were washed three times with PBST and incubated with horseradish
peroxidase-conjugated secondary antibodies for 1 h at room
temperature. After washing three times with PBST, immunoreactive
protein bands were detected using the Odyssey scanning system
(LI-COR, Lincoln, NE, USA).
Statistical analysis
Data are presented as the means ± standard deviation
(SD) from at least three separate experiments. The Student’s t-test
(two-tailed) was used to compare the statistical differences
between the two groups using SPSS 17.0 (SPSS, Inc., Chicago, IL,
USA) statistical software. P<0.05 was considered to indicate
statistically significant results.
Results
miR-183 is upregulated in papillary
thyroid cancer clinical tissues and cell lines
We first determined the expression levels of miR-183
in papillary thyroid cancer and cell lines by RT-qPCR. As shown in
Fig. 1A, the levels of miR-183
showed a 11.59±0.2817-fold higher expression in cancer tissues when
compared with the adjacent normal tissues (P<0.05). Similarly in
comparison with Nthy-ori 3-1, the papillary thyroid cancer cell
lines expressed higher levels of miR-183 (P<0.05; Fig. 1B). These results indicated that
miR-183 was upregulated in papillary thyroid cancer and cell
lines.
miR-183 promotes TPC-1 cell
proliferation
An MTT assay was used to investigate the effects of
miR-183 on papillary thyroid cancer cell proliferation. TPC-1 cells
were treated with 50 and 100 nM miR-183 mimics, miR-183 inhibitor
or miRNA NC for 24, 48, 72 and 96 h and the absorbance was measured
at 490 nm. As shown in Fig. 2A, the
upregulation of miR-183 significantly increased the growth rate of
TPC-1 cells in a dose- and time-dependent manner (P<0.05).
Moreover, the viability of miR-183 inhibitor groups was
consistently significantly lower than that of the miRNA NC groups
(P<0.05, Fig. 2B). Cell
proliferation was markedly enhanced or inhibited when cells were
treated with 100 nM miR-183 mimics or inhibitor for 72 h at a
growth rate of 22.32 and 34.7% (P<0.05) (Fig. 2A and B). Thus, 100 nm was used in
the subsequent experiments. Increased and decreased colony
formation was observed in the miR-183 and miR-183 inhibitor groups
as compared to the miRNA NC group (Fig.
2D). The number of colonies for each group is shown in Fig. 2C. The clone formation of the miRNA
NC group (258.3±20.69) was significantly higher than that of the
miR-183 inhibitor group (88.5±6.18) and lower than that of the
miR-183 mimics group (390.3±15.45) (P<0.05). The results
confirmed that miR-183 promotes TPC-1 cell proliferation.
miR-183 promotes TPC-1 cell migration and
invasion
The wound-healing and Transwell invasion assays were
used to determine whether miR-183 overexpression promotes tumor
aggression. As shown in Fig. 3, the
cells transfected with miRNA NC migrated slower than miR-183 mimics
but more rapidly than the miR-183 inhibitor. The result of the
Transwell assay (Fig. 4A) showed
that the number of TPC-1 cells transfected with miR-183 mimics to
the lower chamber markedly increased compared with miRNA NC,
whereas the number of miR-183 inhibitors markedly decreased
compared with miRNA NC. The quantification results (Fig. 4B) confirmed the results observed by
inverted microscopy. The OD values at 573 nm were: miR-183 mimics
group (0.8347±0.01431), miRNA NC group (0.6327±0.01581) and miR-183
inhibitor group (0.4113±0.01004) (P<0.05). The results indicated
that the overexpression of miR-183 promoted TPC-1 cell migration
and invasion.
miR-183 inhibits apoptosis in TPC-1
cells
To examine whether miR-183 inhibited the apoptosis
of papillary thyroid cancer cells, TPC-1 cells were transfected
with 100 nmol/l of miR-183 mimics, miRNA NC and miR-183 inhibitor
for 36 h. Flow cytometry data (Fig.
5) showed that the number of apoptotic cells was reduced in the
miR-183 mimics group (Q2+Q4=1.5±0.06% apoptotic cells) compared to
the miRNA NC group (Q2+Q4=5.1±0.08% apoptotic cells) (P<0.05).
However, the number of apoptotic cells in the miR-183 inhibitor
group (Q2+Q4=7.8±0.07% apoptotic cells) was markedly increased
(P<0.05). These results indicated that miR-183 inhibited
apoptosis in TPC-1 cells.
PDCD4 is a direct target of miR-183
To determine whether PDCD4 is a direct target of
miR-183, the 3′-UTR of PDCD4 mRNA containing the miR-183 binding
sites and the mutant were cloned into a luciferase reporter
construct. The luciferase reporter assay (Fig. 6B) showed that the relative
luciferase activity (RL/FL) of miR-183 mimics co-transfection of
the PDCD4-wt-vector group was significantly decreased compared with
the NC. However, this effect of miR-183 was abolished following the
co-transfection of PDCD4-mut-vector. These results indicated that
PDCD4 is a direct target of miR-183.
miR-183 negatively regulates PDCD4
protein expression at the post-transcriptional level
To determine the relationship between miR-183 and
PDCD4 at the mRNA and protein levels, miR-183 mimics, inhibitors or
miRNA NC (100 nmol/l) were transfected into TPC-1 cells, and the
levels of PDCD4 mRNA and protein were monitored. The RT-qPCR
analysis showed that PDCD4 mRNA levels were not significantly
altered during these treatments (Fig.
7A). However, western blot analysis revealed that compared to
the controls, the expression of PDCD4 was significantly reduced by
miR-183 mimics transfection and increased by miR-183 inhibitor
transfection (Fig. 7B). The results
indicated that miR-183 did not affect mRNA stability and regulated
PDCD4 expression at the post-transcriptional level.
PDCD4 is involved in miR-183-induced
effects in PTC cells
To determine whether PDCD4 serves as a critical
mediator of the role of miR-183 in PTC cells, PDCD4 and NC siRNAs
were transfected into TPC-1 cells. As shown in Fig. 8H, the protein level of PDCD4 was
decreased in TPC-1 cells transfected with PDCD4 siRNA compared with
NC siRNA. In the MTT assay, compared with the NC siRNA group, the
PDCD4 siRNA group markedly increased cell proliferation by 33.4,
65.4 and 44.4% at 48, 72 and 96 h, respectively (P<0.05;
Fig. 8A). Moreover, cell colony
formation efficiency increased in the PDCD4 siRNA group (P<0.05
Fig. 8B and C). Knockdown of PDCD4
promoted the migration and invasion ability of TPC-1 cells
(P<0.05; Fig. 8D, E and G). The
apoptosis assay demonstrated knockdown of PDCD4 decreased TPC-1
cell apoptosis by 90% at 36 h after transfection (Fig. 8F). These data indicated that effects
of siRNA versus PDCD4 were similar to those induced by miR-183 in
TPC-1 cells, rendering PDCD4 as a functional target of miR-183.
Discussion
Mounting evidence has indicated that miRNAs
contribute to cancer pathogenesis. Thus, understanding the
relationship between miRNAs and its targets and cell signaling
pathways involved in cancer became important. miR-183 is a member
of the miR-183-96-182 cluster, located at the human 7q31–34 locus
and which contains highly conserved sequences (37–40).
It has been found to be dysregulated in a variety of different
solid tumors. miR-183 is downregulated in lung cancer cells
(41), osteosarcoma (42,43)
and breast cancer (44). However,
it is upregulated in prostate cancer (39,45–47),
hepatocellular carcinoma (HCC) (48–50),
colon cancer (38, 51–54)
and medullary thyroid carcinoma (55). The different expression profiles may
be tissue- and cell type-specific. The abovementioned studies
reported that miR-183 is involved in cell differentiation,
proliferation, migration, invasion and apoptosis. This finding
suggested that miR-183 plays a critical role in tumorigenesis and
serves as an oncogene or tumor-suppressor gene in several types of
cancer. However, the exact role of miR-183 in PTC is not fully
understood.
In the present study, we determined that the
expression level of miR-183 was significantly upregulated in PTC
tissues and the Nthy-ori 3-1 cell line compared with adjacent
normal tissues and the four PTC cell lines. The functional assays
demonstrated that overexpression of miR-183 markedly promoted
proliferation, migration, invasion and suppressed the apoptosis of
TPC-1 cells. These results suggest that miR-183 functions as an
oncogene in TPC.
Many targets of miRNA-183 have been identified
including ezrin (41,43,56,57),
ViL2 (44), EGR1 (38), SMAD4, Dkk-3 (40), LRP6 (58), IDH2 (59), ITGB1, KIF2A (60) and Tiam1 (61). Although PDCD4 was identified as one
of the targets of miR-183 in human HCC cells (34) and oesophageal squamous cell
carcinoma (35), the effect of
miR-183 on PTC through the PDCD4 pathway was unknown.
The PDCD4 gene is located at chromosome 10q24
and was first isolated from a human glioma cDNA library as a
tumor-associated gene (62,63). Previous results indicated that PDCD4
expression is downregulated or lost in several tumor types as a
novel tumor suppressor (24,25,64–67).
Additionally, PDCD4 is involved in tumor progression: cell
proliferation, invasion, metastasis and neoplastic transformation
in breast cancer (67–69); proliferation and invasion in
esophageal squamous cell carcinoma (70); invasion, intravasation and
metastasis in colon cancer (71);
and cell proliferation, invasion and apoptosis in TPC-1 (32). The abovementioned data suggested
that PDCD4 is a critical regulator in many human malignancies.
The PDCD4 protein influences protein translation by
binding eukaryotic translation initiation factor 4A (eIF4A)
(72,73) and reducing growth advantages of the
cells and development of cancer by inhibiting activator protein 1
(AP-1)-mediated transactivation (74). Another protein that is regulated by
PDCD4 is carbonic anhydrase type II (CA II) (75), which contributes to the
tumor-suppressor function. PDCD4 inhibits tumor cell invasion and
metastasis by downregulating urokinase receptor (uPAR) which
mediates the degradation of extracellular matrix components
(74). In addition, PDCD4
influences cell cycle progression by inducing p21Waf1/Cip1
(25). PDCD4 has also been found to
be involved in the PI3K/AKT pathway (76), β-catenin, and T-cell factor pathway
(77). Moreover, PDCD4 can be
induced by the cyclooxygenase-2 (COX-2) inhibitor, retinoic acid
receptor (RAR) agonists (78),
transforming growth factor-β (TGF-β) (66), and be downregulated by miR-21
(71,79,80).
In the present study, the luciferase reporter assay
confirmed that PDCD4 was a direct target of miR-183. Additionally,
the knockdown of PDCD4 by siRNA in PTC1 cells significantly
enhanced cell proliferation, migration and invasion and reduced
apoptosis, consistent with the results of teh overexpression
miR-183 in PTC1 cells. The western blot analysis revealed that
protein was decreased in TPC-1 cells following the upregulation of
miR-183. These findings suggest that PDCD4 was an important target
of miR-183 in the TPC-1 cell line. miR-183 regulates cell functions
by directly targeting PDCD4 in PTC1 cells. Furthermore, RT-qPCR
results showed no differences in miR-183 overexpressing cells in
PDCD4 mRNA levels. These results indicate that miR-183 negatively
regulates endogenous PDCD4 protein expression at the
post-transcriptional level but not at the mRNA level.
In summary, the present study has demonstrated that
miR-183 was upregulated in TPC tissues and cell lines, and was able
to promote cell proliferation, migration, invasion and suppress
apoptosis by negatively regulating the expression of PDCD4 protein
at the post-transcriptional level in TPC-1 cells. Therefore, the
findings of the present study reveal a viable approach for the
diagnosis of PTC, and provide a novel molecular target for PTC
therapy.
Acknowledgments
This study was made possible with financial support
from the National Natural Sciences Foundation of China (no.
81272240), and the Institutional Ethics Committee of Shanghai Tenth
People’s Hospital. Furthermore, we extend special thanks to all the
teachers at the Central Laboratory of the Shanghai Tenth People’s
hospital for their assistance and support.
References
|
1
|
Leenhardt L, Grosclaude P and
Chérié-Challine L: Thyroid Cancer Committee: Increased incidence of
thyroid carcinoma in France: A true epidemic or thyroid nodule
management effects? Report from the French Thyroid Cancer
Committee. Thyroid. 14:1056–1060. 2004. View Article : Google Scholar
|
|
2
|
Davies L and Welch HG: Increasing
incidence of thyroid cancer in the United States, 1973–2002. JAMA.
295:2164–2167. 2006. View Article : Google Scholar : PubMed/NCBI
|
|
3
|
Schmid KW: Molecular pathology of thyroid
tumors. Pathologe. 31(Suppl 2): 229–233. 2010.In German. View Article : Google Scholar
|
|
4
|
Siegel R, Naishadham D and Jemal A: Cancer
statistics for Hispanics/Latinos, 2012. CA Cancer J Clin.
62:283–298. 2012. View Article : Google Scholar : PubMed/NCBI
|
|
5
|
Loh KC, Greenspan FS, Gee L, Miller TR and
Yeo PP: Pathological tumor-node-metastasis (pTNM) staging for
papillary and follicular thyroid carcinomas: A retrospective
analysis of 700 patients. J Clin Endocrinol Metab. 82:3553–3562.
1997. View Article : Google Scholar : PubMed/NCBI
|
|
6
|
Chi SW, Zang JB, Mele A and Darnell RB:
Argonaute HiTS-CLiP decodes microRNA-mRNA interaction maps. Nature.
460:479–486. 2009.PubMed/NCBI
|
|
7
|
Hale BJ, Yang CX and Ross JW: Small RNA
regulation of reproductive function. Mol Reprod Dev. 81:148–159.
2014. View Article : Google Scholar
|
|
8
|
Bartel DP: MicroRNAs: Genomics,
biogenesis, mechanism, and function. Cell. 116:281–297. 2004.
View Article : Google Scholar : PubMed/NCBI
|
|
9
|
Vohradsky J, Panek J and Vomastek T:
Numerical modelling of microRNA-mediated mRNA decay identifies
novel mechanism of microRNA controlled mRNA downregulation. Nucleic
Acids Res. 38:4579–4585. 2010. View Article : Google Scholar : PubMed/NCBI
|
|
10
|
Chu C and Zhao Z: MicroRNA in the
molecular mechanism of the circadian clock in mammals. Front
Biosci. 18:441–446. 2013. View
Article : Google Scholar
|
|
11
|
Miska EA: How microRNAs control cell
division, differentiation and death. Curr Opin Genet Dev.
15:563–568. 2005. View Article : Google Scholar : PubMed/NCBI
|
|
12
|
Hwang HW and Mendell JT: MicroRNAs in cell
proliferation, cell death, and tumorigenesis. Br J Cancer.
94:776–780. 2006. View Article : Google Scholar : PubMed/NCBI
|
|
13
|
Calin GA and Croce CM: MicroRNA signatures
in human cancers. Nat Rev Cancer. 6:857–866. 2006. View Article : Google Scholar : PubMed/NCBI
|
|
14
|
Dykxhoorn DM: MicroRNAs and metastasis:
Little RNAs go a long way. Cancer Res. 70:6401–6406. 2010.
View Article : Google Scholar : PubMed/NCBI
|
|
15
|
Calin GA, Sevignani C, Dumitru CD, Hyslop
T, Noch E, Yendamuri S, Shimizu M, Rattan S, Bullrich F, Negrini M,
et al: Human microRNA genes are frequently located at fragile sites
and genomic regions involved in cancers. Proc Natl Acad Sci USA.
101:2999–3004. 2004. View Article : Google Scholar : PubMed/NCBI
|
|
16
|
Gao Y, Wang C, Shan Z, Guan H, Mao J, Fan
C, Wang H, Zhang H and Teng W: miRNA expression in a human
papillary thyroid carcinoma cell line varies with invasiveness.
Endocr J. 57:81–86. 2010. View Article : Google Scholar
|
|
17
|
Menon MP and Khan A: Micro-RNAs in thyroid
neoplasms: Molecular, diagnostic and therapeutic implications. J
Clin Pathol. 62:978–985. 2009. View Article : Google Scholar : PubMed/NCBI
|
|
18
|
Nikiforova MN, Chiosea SI and Nikiforov
YE: MicroRNA expression profiles in thyroid tumors. Endocr Pathol.
20:85–91. 2009. View Article : Google Scholar : PubMed/NCBI
|
|
19
|
Srivastava A, Goldberger H, Dimtchev A,
Ramalinga M, Chijioke J, Mrian C, Oermann EK, Uhm S, Kim JS, Chen
LN, et al: MicroRNA profiling in prostate cancer - the diagnostic
potential of urinary miR-205 and miR-214. PLoS One. 8:e769942013.
View Article : Google Scholar :
|
|
20
|
Hodge LS, Elsawa SF, Grote DM,
Price-Troska TL, Asmann YW, Fonseca R, Gertz MA, Witzig TE, Novak
AJ and Ansell SM: MicroRNA expression in tumor cells from
Waldenstrom’s macroglobulinemia reflects both their normal and
malignant cell counterparts. Blood Cancer J. 1:e242011. View Article : Google Scholar
|
|
21
|
He H, Jazdzewski K, Li W, Liyanarachchi S,
Nagy R, Volinia S, Calin GA, Liu CG, Franssila K, Suster S, et al:
The role of microRNA genes in papillary thyroid carcinoma. Proc
Natl Acad Sci USA. 102:19075–19080. 2005. View Article : Google Scholar : PubMed/NCBI
|
|
22
|
Tetzlaff MT, Liu A, Xu X, Master SR,
Baldwin DA, Tobias JW, Livolsi VA and Baloch ZW: Differential
expression of miRNAs in papillary thyroid carcinoma compared to
multinodular goiter using formalin fixed paraffin embedded tissues.
Endocr Pathol. 18:163–173. 2007. View Article : Google Scholar : PubMed/NCBI
|
|
23
|
Pallante P, Visone R, Ferracin M, Ferraro
A, Berlingieri MT, Troncone G, Chiappetta G, Liu CG, Santoro M,
Negrini M, et al: MicroRNA deregulation in human thyroid papillary
carcinomas. Endocr Relat Cancer. 13:497–508. 2006. View Article : Google Scholar : PubMed/NCBI
|
|
24
|
Jansen AP, Camalier CE, Stark C and
Colburn NH: Characterization of programmed cell death 4 in multiple
human cancers reveals a novel enhancer of drug sensitivity. Mol
Cancer Ther. 3:103–110. 2004.PubMed/NCBI
|
|
25
|
Göke R, Barth P, Schmidt A, Samans B and
Lankat-Buttgereit B: Programmed cell death protein 4 suppresses
CDK1/cdc2 via induction of p21Waf1/Cip1. Am J Physiol
Cell Physiol. 287:C1541–C1546. 2004. View Article : Google Scholar
|
|
26
|
Vikhreva PN, Shepelev MV, Korobko EV and
Korobko IV: Pdcd4 tumor suppressor: Properties, functions, and
their application to oncology. Mol Gen Mikrobiol Virusol. 2:3–11.
2010.In Russian.
|
|
27
|
Young MR, Santhanam AN, Yoshikawa N and
Colburn NH: Have tumor suppressor PDCD4 and its counteragent
oncogenic miR-21 gone rogue? Mol Interv. 10:76–79. 2010. View Article : Google Scholar : PubMed/NCBI
|
|
28
|
Allgayer H: Pdcd4, a colon cancer
prognostic that is regulated by a microRNA. Crit Rev Oncol Hematol.
73:185–191. 2010. View Article : Google Scholar
|
|
29
|
Fassan M, Pizzi M, Battaglia G, Giacomelli
L, Parente P, Bocus P, Ancona E and Rugge M: Programmed cell death
4 (PDCD4) expression during multistep Barrett’s carcinogenesis. J
Clin Pathol. 63:692–696. 2010. View Article : Google Scholar : PubMed/NCBI
|
|
30
|
Fassan M, Pizzi M, Giacomelli L, Mescoli
C, Ludwig K, Pucciarelli S and Rugge M: PDCD4 nuclear loss
inversely correlates with miR-21 levels in colon carcinogenesis.
Virchows Arch. 458:413–419. 2011. View Article : Google Scholar : PubMed/NCBI
|
|
31
|
Fassan M, Realdon S, Pizzi M, Balistreri
M, Battaglia G, Zaninotto G, Ancona E and Rugge M: Programmed cell
death 4 nuclear loss and miR-21 or activated Akt overexpression in
esophageal squamous cell carcinogenesis. Dis Esophagus. 25:263–268.
2012. View Article : Google Scholar
|
|
32
|
Zhang J, Yang Y, Liu Y, Fan Y, Liu Z, Wang
X, Yuan Q, Yin Y, Yu J, Zhu M, et al: MicroRNA-21 regulates
biological behaviors in papillary thyroid carcinoma by targeting
programmed cell death 4. J Surg Res. 189:68–74. 2014. View Article : Google Scholar : PubMed/NCBI
|
|
33
|
Pennelli G, Fassan M, Mian C, Pizzi M,
Balistreri M, Barollo S, Galuppini F, Guzzardo V, Pelizzo M and
Rugge M: PDCD4 expression in thyroid neoplasia. Virchows Arch.
462:95–100. 2013. View Article : Google Scholar
|
|
34
|
Li J, Fu H, Xu C, Tie Y, Xing R, Zhu J,
Qin Y, Sun Z and Zheng X: miR-183 inhibits TGF-beta1-induced
apoptosis by downregulation of PDCD4 expression in human
hepatocellular carcinoma cells. BMC Cancer. 10:3542010. View Article : Google Scholar : PubMed/NCBI
|
|
35
|
Ren LH, Chen WX, Li S, He XY, Zhang ZM, Li
M, Cao RS, Hao B, Zhang HJ, Qiu HQ, et al: MicroRNA-183 promotes
proliferation and invasion in oesophageal squamous cell carcinoma
by targeting programmed cell death 4. Br J Cancer. 111:2003–2013.
2014. View Article : Google Scholar : PubMed/NCBI
|
|
36
|
Livak KJ and Schmittgen TD: Analysis of
relative gene expression data using real-time quantitative PCR and
the 2−ΔΔCT Method. Methods.
25:402–408. 2001. View Article : Google Scholar
|
|
37
|
Bastian BC, LeBoit PE, Hamm H, Bröcker EB
and Pinkel D: Chromosomal gains and losses in primary cutaneous
melanomas detected by comparative genomic hybridization. Cancer
Res. 58:2170–2175. 1998.PubMed/NCBI
|
|
38
|
Sarver AL, Li L and Subramanian S:
MicroRNA miR-183 functions as an oncogene by targeting the
transcription factor EGR1 and promoting tumor cell migration.
Cancer Res. 70:9570–9580. 2010. View Article : Google Scholar : PubMed/NCBI
|
|
39
|
Mihelich BL, Khramtsova EA, Arva N,
Vaishnav A, Johnson DN, Giangreco AA, Martens-Uzunova E, Bagasra O,
Kajdacsy-Balla A and Nonn L: miR-183-96-182 cluster is
overexpressed in prostate tissue and regulates zinc homeostasis in
prostate cells. J Biol Chem. 286:44503–44511. 2011. View Article : Google Scholar : PubMed/NCBI
|
|
40
|
Ueno K, Hirata H, Shahryari V, Deng G,
Tanaka Y, Tabatabai ZL and Hinoda Yand Dahiya R: microRNA-183 is an
oncogene targeting Dkk-3 and SMAD4 in prostate cancer. Br J Cancer.
108:1659–1667. 2013. View Article : Google Scholar : PubMed/NCBI
|
|
41
|
Wang G, Mao W and Zheng S: MicroRNA-183
regulates Ezrin expression in lung cancer cells. FEBS Lett.
582:3663–3668. 2008. View Article : Google Scholar : PubMed/NCBI
|
|
42
|
Mu Y, Zhang H, Che L and Li K: Clinical
significance of microRNA-183/Ezrin axis in judging the prognosis of
patients with osteosarcoma. Med Oncol. 31:8212014. View Article : Google Scholar
|
|
43
|
Zhu J, Feng Y, Ke Z, Yang Z, Zhou J, Huang
X and Wang L: Down-regulation of miR-183 promotes migration and
invasion of osteosarcoma by targeting Ezrin. Am J Pathol.
180:2440–2451. 2012. View Article : Google Scholar : PubMed/NCBI
|
|
44
|
Lowery AJ, Miller N, Dwyer RM and Kerin
MJ: Dysregulated miR-183 inhibits migration in breast cancer cells.
BMC Cancer. 10:5022010. View Article : Google Scholar : PubMed/NCBI
|
|
45
|
Tsuchiyama K, Ito H, Taga M, Naganuma S,
Oshinoya Y, Nagano K, Yokoyama O and Itoh H: Expression of
microRNAs associated with Gleason grading system in prostate
cancer: miR-182-5p is a useful marker for high grade prostate
cancer. Prostate. 73:827–834. 2013. View Article : Google Scholar
|
|
46
|
Schaefer A, Jung M, Mollenkopf HJ, Wagner
I, Stephan C, Jentzmik F, Miller K, Lein M, Kristiansen G and Jung
K: Diagnostic and prognostic implications of microRNA profiling in
prostate carcinoma. Int J Cancer. 126:1166–1176. 2010.
|
|
47
|
Larne O, Martens-Uzunova E, Hagman Z,
Edsjö A, Lippolis G, den Berg MS, Bjartell A, Jenster G and Ceder
Y: miQ - a novel microRNA based diagnostic and prognostic tool for
prostate cancer. Int J Cancer. 132:2867–2875. 2013. View Article : Google Scholar
|
|
48
|
Goeppert B, Schmezer P, Dutruel C, Oakes
C, Renner M, Breinig M, Warth A, Vogel MN, Mittelbronn M, Mehrabi
A, et al: Down-regulation of tumor suppressor A kinase anchor
protein 12 in human hepatocarcinogenesis by epigenetic mechanisms.
Hepatology. 52:2023–2033. 2010. View Article : Google Scholar : PubMed/NCBI
|
|
49
|
Liu AM, Yao TJ, Wang W, Wong KF, Lee NP,
Fan ST, Poon RT, Gao C and Luk JM: Circulating miR-15b and miR-130b
in serum as potential markers for detecting hepatocellular
carcinoma: A retrospective cohort study. BMJ Open. 2:e0008252012.
View Article : Google Scholar : PubMed/NCBI
|
|
50
|
Liang Z, Gao Y, Shi W, Zhai D, Li S, Jing
L, Guo H, Liu T, Wang Y and Du Z: Expression and significance of
microRNA-183 in hepatocellular carcinoma. Sci World J.
2013:3818742013. View Article : Google Scholar
|
|
51
|
Sarver AL, French AJ, Borralho PM,
Thayanithy V, Oberg AL, Silverstein KA, Morlan BW, Riska SM,
Boardman LA, Cunningham JM, et al: Human colon cancer profiles show
differential microRNA expression depending on mismatch repair
status and are characteristic of undifferentiated proliferative
states. BMC Cancer. 9:4012009. View Article : Google Scholar : PubMed/NCBI
|
|
52
|
Motoyama K, Inoue H, Takatsuno Y, Tanaka
F, Mimori K, Uetake H, Sugihara K and Mori M: Over- and
under-expressed microRNAs in human colorectal cancer. Int J Oncol.
34:1069–1075. 2009.PubMed/NCBI
|
|
53
|
Earle JS, Luthra R, Romans A, Abraham R,
Ensor J, Yao H and Hamilton SR: Association of microRNA expression
with microsatellite instability status in colorectal
adenocarcinoma. J Mol Diagn. 12:433–440. 2010. View Article : Google Scholar : PubMed/NCBI
|
|
54
|
Li X, Zhang G, Luo F, Ruan J, Huang D,
Feng D, Xiao D, Zeng Z, Chen X and Wu W: Identification of
aberrantly expressed miRNAs in rectal cancer. Oncol Rep. 28:77–84.
2012.PubMed/NCBI
|
|
55
|
Mian C, Pennelli G, Fassan M, Balistreri
M, Barollo S, Cavedon E, Galuppini F, Pizzi M, Vianello F, Pelizzo
MR, et al: microRNA profiles in familial and sporadic medullary
thyroid carcinoma: Preliminary relationships with RET status and
outcome. Thyroid. 22:890–896. 2012. View Article : Google Scholar : PubMed/NCBI
|
|
56
|
Zhao H, Guo M, Zhao G, Ma Q, Ma B, Qiu X
and Fan Q: miR-183 inhibits the metastasis of osteosarcoma via
downregulation of the expression of Ezrin in F5M2 cells. Int J Mol
Med. 30:1013–1020. 2012.PubMed/NCBI
|
|
57
|
Li J, Liang SH and Lu X: Potential role of
ezrin and its related microRNA in ovarian cancer invasion and
metastasis. Zhonghua Fu Chan Ke Za Zhi. 45:787–792. 2010.in
Chinese. PubMed/NCBI
|
|
58
|
Wang J, Wang X, Li Z, Liu H and Teng Y:
microRNA-183 suppresses retinoblastoma cell growth, invasion and
migration by targeting LRP6. FEBS J. 281:1355–1365. 2014.
View Article : Google Scholar
|
|
59
|
Tanaka H, Sasayama T, Tanaka K, Nakamizo
S, Nishihara M, Mizukawa K, Kohta M, Koyama J, Miyake S, Taniguchi
M, et al: microRNA-183 upregulates HiF-1α by targeting isocitrate
dehydrogenase 2 (iDH2) in glioma cells. J Neurooncol. 111:273–283.
2013. View Article : Google Scholar
|
|
60
|
Li G, Luna C, Qiu J, Epstein DL and
Gonzalez P: Targeting of integrin beta1 and kinesin 2alpha by
microRNA 183. J Biol Chem. 285:5461–5471. 2010. View Article : Google Scholar :
|
|
61
|
Li J, Liang S, Jin H, Xu C, Ma D and Lu X:
Tiam1, negatively regulated by miR-22, miR-183 and miR-31, is
involved in migration, invasion and viability of ovarian cancer
cells. Oncol Rep. 27:1835–1842. 2012.PubMed/NCBI
|
|
62
|
Soejima H, Miyoshi O, Yoshinaga H, Masaki
Z, Ozaki I, Kajiwara S, Niikawa N, Matsuhashi S and Mukai T:
Assignment of the programmed cell death 4 gene (PDCD4) to human
chromosome band 10q24 by in situ hybridization. Cytogenet Cell
Genet. 87:113–114. 1999. View Article : Google Scholar
|
|
63
|
Cmarik JL, Min H, Hegamyer G, Zhan S,
Kulesz-Martin M, Yoshinaga H, Matsuhashi S and Colburn NH:
Differentially expressed protein Pdcd4 inhibits tumor
promoter-induced neoplastic transformation. Proc Natl Acad Sci USA.
96:14037–14042. 1999. View Article : Google Scholar : PubMed/NCBI
|
|
64
|
Young MR, Yang HS and Colburn NH:
Promising molecular targets for cancer prevention: AP-1, NF-kappa B
and Pdcd4. Trends Mol Med. 9:36–41. 2003. View Article : Google Scholar : PubMed/NCBI
|
|
65
|
Afonja O, Juste D, Das S, matsuhashi S and
Samuels HH: Induction of PDCD4 tumor suppressor gene expression by
RAR agonists, antiestrogen and HER-2/neu antagonist in breast
cancer cells. Evidence for a role in apoptosis. Oncogene.
23:8135–8145. 2004. View Article : Google Scholar : PubMed/NCBI
|
|
66
|
Zhang H, Ozaki I, Mizuta T, Hamajima H,
Yasutake T, Eguchi Y, Ideguchi H, Yamamoto K and Matsuhashi S:
Involvement of programmed cell death 4 in transforming growth
factorbeta1-induced apoptosis in human hepatocellular carcinoma.
Oncogene. 25:6101–6112. 2006. View Article : Google Scholar : PubMed/NCBI
|
|
67
|
Frankel LB, Christoffersen NR, Jacobsen A,
Lindow M, Krogh A and Lund AH: Programmed cell death 4 (PDCD4) is
an important functional target of the microRNA miR-21 in breast
cancer cells. J Biol Chem. 283:1026–1033. 2008. View Article : Google Scholar
|
|
68
|
Zhu S, Wu H, Wu F, Nie D, Sheng S and mo
YY: MicroRNA-21 targets tumor suppressor genes in invasion and
metastasis. Cell Res. 18:350–359. 2008. View Article : Google Scholar : PubMed/NCBI
|
|
69
|
Lu Z, Liu M, Stribinskis V, Klinge CM,
Ramos KS, Colburn NH and Li Y: MicroRNA-21 promotes cell
transformation by targeting the programmed cell death 4 gene.
Oncogene. 27:4373–4379. 2008. View Article : Google Scholar : PubMed/NCBI
|
|
70
|
Hiyoshi Y, Kamohara H, Karashima R, Sato
N, Imamura Y, Nagai Y, Yoshida N, Toyama E, Hayashi N, Watanabe M,
et al: MicroRNA-21 regulates the proliferation and invasion in
esophageal squamous cell carcinoma. Clin Cancer Res. 15:1915–1922.
2009. View Article : Google Scholar : PubMed/NCBI
|
|
71
|
Asangani IA, Rasheed SA, Nikolova DA,
Leupold JH, Colburn NH, Post S and Allgayer H: MicroRNA-21 (miR-21)
post-transcriptionally downregulates tumor suppressor Pdcd4 and
stimulates invasion, intravasation and metastasis in colorectal
cancer. Oncogene. 27:2128–2136. 2008. View Article : Google Scholar
|
|
72
|
Göke A, Göke R, Knolle A, Trusheim H,
Schmidt H, Wilmen A, Carmody R, Göke B and Chen YH: DUG is a novel
homologue of translation initiation factor 4G that binds eIF4A.
Biochem Biophys Res Commun. 297:78–82. 2002. View Article : Google Scholar : PubMed/NCBI
|
|
73
|
Yang HS, Jansen AP, Komar AA, Zheng X,
Merrick WC, Costes S, Lockett SJ, Sonenberg N and Colburn NH: The
transformation suppressor Pdcd4 is a novel eukaryotic translation
initiation factor 4A binding protein that inhibits translation. Mol
Cell Biol. 23:26–37. 2003. View Article : Google Scholar :
|
|
74
|
Leupold JH, Yang HS, Colburn NH, Asangani
I, Post S and Allgayer H: Tumor suppressor Pdcd4 inhibits
invasion/intravasation and regulates urokinase receptor (u-PAR)
gene expression via Sp-transcription factors. Oncogene.
26:4550–4562. 2007. View Article : Google Scholar : PubMed/NCBI
|
|
75
|
Lankat-Buttgereit B, Gregel C, Knolle A,
Hasilik A, Arnold R and Göke R: Pdcd4 inhibits growth of tumor
cells by suppression of carbonic anhydrase type II. Mol Cell
Endocrinol. 214:149–153. 2004. View Article : Google Scholar : PubMed/NCBI
|
|
76
|
Wang WQ, Zhang H, Wang HB, Sun YG, Peng
ZH, Zhou G, Yang SM, Wang RQ and Fang DC: Programmed cell death 4
(PDCD4) enhances the sensitivity of gastric cancer cells to
TRAIL-induced apoptosis by inhibiting the PI3K/Akt signaling
pathway. Mol Diagn Ther. 14:155–161. 2010. View Article : Google Scholar : PubMed/NCBI
|
|
77
|
Wang Q, Sun Z and Yang HS: Downregulation
of tumor suppressor Pdcd4 promotes invasion and activates both
betacatenin/Tcf and AP-1-dependent transcription in colon carcinoma
cells. Oncogene. 27:1527–1535. 2008. View Article : Google Scholar
|
|
78
|
Zhang Z and DuBois RN: Detection of
differentially expressed genes in human colon carcinoma cells
treated with a selective COX-2 inhibitor. Oncogene. 20:4450–4456.
2001. View Article : Google Scholar : PubMed/NCBI
|
|
79
|
Yang Y, Meng H, Peng Q, Yang X, Gan R,
Zhao L, Chen Z, Lu J and Meng QH: Downregulation of microRNA-21
expression restrains non-small cell lung cancer cell proliferation
and migration through upregulation of programmed cell death 4.
Cancer Gene Ther. 22:23–29. 2015. View Article : Google Scholar
|
|
80
|
Luo F, Ji J, Liu Y, Xu Y, Zheng G, Jing J,
Wang B, Xu W, Shi L, Lu X, et al: MicroRNA-21, up-regulated by
arsenite, directs the epithelial-mesenchymal transition and
enhances the invasive potential of transformed human bronchial
epithelial cells by targeting PDCD4. Toxicol Lett. 232:301–309.
2014. View Article : Google Scholar : PubMed/NCBI
|